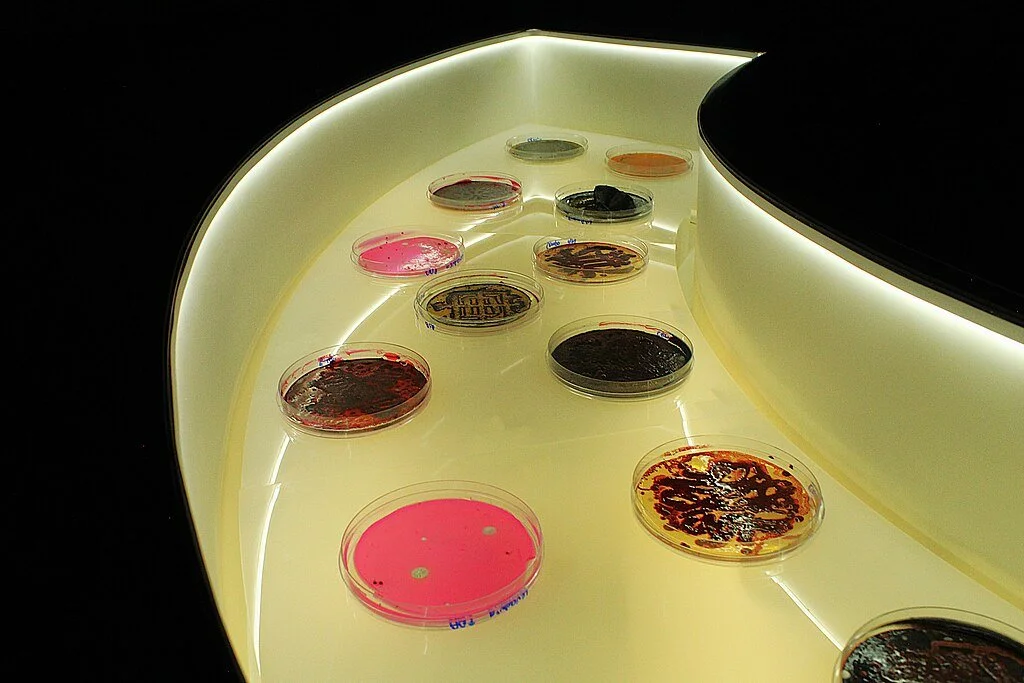

Diari d’arte di novembre
Il diario artistico di novembre si apre con mostre di artisti (tra cui Lakwena Maciver, Hannah Rose Thomas, Tuli Mekondjo e Paul B. Kincaid) su cui ho scritto in precedenza o con cui ho collaborato, e con spazi espositivi legati da affinità simili, soprattutto da un rapporto con la spiritualità. Seguono poi esposizioni dedicate a figure di rilievo che hanno avuto — o hanno tuttora — ispirazioni spirituali, tra cui Stanley Spencer, Sister Corita Kent, Sean Scully ed Edmund de Waal. Concludo con diverse mostre a tema ambientale presso The Arc, il Museo Nacional Thyssen-Bornemisza e il Nevada Museum of Art, oltre a una mostra a Città del Messico dedicata al tema del fallimento.
“LAKWENA – HOW WE BUILD A HOME” è una nuova e vibrante esposizione di dipinti in cartone e perline di Lakwena Maciver al Wellington Arch. In questo nuovo corpus di opere, realizzate con scatole di cartone recuperate e perline di plastica, Maciver trasforma i residui del commercio in pitture grafiche e luminose, rielaborando il linguaggio della mercificazione in affermazioni audaci e promemoria di speranza, bellezza e senso di casa.